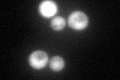
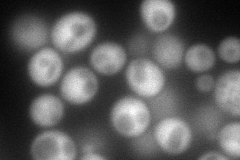
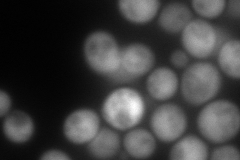
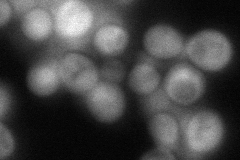
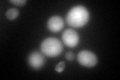
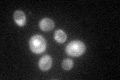

View description
Copper chaperone for superoxide dismutase Sod1p, involved in oxidative stress protection; Met-X-Cys-X2-Cys motif within the N-terminal portion is involved in insertion of copper into Sod1p under conditions of copper deprivation
Localization:
Intensity:
Fold change:
Significance:
-
C’ GFP library in SD
cytosol119.63 -
N' NOP1pr-GFP in SD
cytosol159.288 -
N' TEF2pr-mCherry in SD
cytosol261.526 -
N' NATIVEpr-GFP in SD
cytosol64.9027 -
N' TEF2pr-VC and Cyto-VN in SD

#N/A0 -
C’ GFP library in SD+DTT
cytosol121.831.01No -
C’ GFP library in SD+H2O2

cytosol91.620.76No -
C’ GFP library in Starvation Media
cytosol79.860.66No -
C’ GFP library on the background of Pup2-DaMP

cytosol -
C’ GFP library on the background of CCT mutant

cytosol112.4450.939879No
